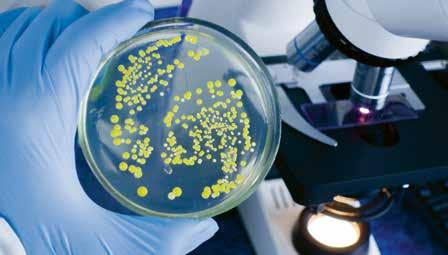

WOORDENLIJST
STUDIEWIJZER
Voortplanting bij planten ISAAC-moment
ISAAC-actie
![]()

WOORDENLIJST
STUDIEWIJZER
Voortplanting bij planten ISAAC-moment
ISAAC-actie
Doorheen de geschiedenis van de aarde zijn soorten ontstaan. Zo zou de huidige mens zo’n 200 000 jaar geleden in Oost-Afrika zijn ontstaan. De evolutie van de mens blijft echter een ingewikkeld verhaal. Er zijn dan ook verschillende theorieën die een verklaring proberen te geven aan dit complex onderwerp.
Hieronder vind je enkele afbeeldingen. Koppel de juiste afbeelding telkens aan de passende uitspraak onderaan de pagina. Doe dat door het cijfer van de uitspraak bij de juiste afbeelding te noteren.


2
Een vrouwtjespauw kiest haar partner op basis van de kleurrijke staart van het mannetje. Die met de mooiste staarten paren dan ook vaker. Tegenwoordig hebben bijna alle mannetjespauwen mooie, glanzende staarten. Als de staart echter té lang wordt, kan het dan weer een last worden voor de vogel en zijn overlevingskansen verkleinen. Dat noemen we evolutie op basis van natuurlijke selectie.

Een smid zal door zijn werk sterke armspieren ontwikkelen. Daarom zullen zijn kinderen ook met gespierde armen worden geboren. Op dezelfde manier zal het veulen van een giraf een langere nek hebben dan zijn ouders. Die hebben hun nekspieren immers getraind in het reiken naar hoog gebladerte.
Kwallen bestaan al 550 miljoen jaar in een gelijkaardige vorm. Ook schildpadden zijn nauwelijks veranderd: het schild en nog andere kenmerken kwamen al voor bij fossielen van 200 miljoen jaar geleden. Soorten veranderen dus niet. 3
Welke visie op ontstaan en evolutie is volgens jou de correcte? Markeer en bespreek.
Bekijk het filmpje over soortvorming. Wat kun je hieruit besluiten? Noteer.
Ondanks de nauwe genetische verwantschap zijn mensen en chimpansees twee verschillende soorten en kunnen zich onderling dus niet voortplanten. De mens blijft echter een zeer nieuwsgierig wezen. Zo ondernam de Rus Ilja Ivanov aan het begin van de 20e eeuw een aantal pogingen om chimpansees en mensen met elkaar te kruisen door middel van kunstmatige inseminatie. Van zo’n hybride of kruising, die men ook wel ‘humanzee’ noemt in het Engels, is er echter geen enkel bewijs. Bovendien beschouwt men deze experimenten als onethisch en immoreel.
1.1 Wat is voortplanting?
Het ontstaan van soorten en het evolueren ervan gebeurt pas als er sprake is van voortplanting. Hoe zou jij voortplanting omschrijven?
Vul de mindmap hieronder aan met woorden die het begrip voortplanting omschrijven. Bespreek.
Voortplanting
Verbind de afbeeldingen die samenhoren met elkaar.








Welke relatie bestaat er tussen de organismen die je met elkaar verbonden hebt?
Waarom is het belangrijk dat organismen zich voortplanten?
Kruis aan of volgende organismen kunnen zorgen voor nakomelingen of niet. Noteer ook steeds een verklaring voor je antwoord.
organismen

Hert (mannelijk) en hert (vrouwelijk)

Mens (mannelijk) en mens (mannelijk)


Tulp (mannelijk) en zonnebloem (vrouwelijk)

Aardappelplant
kunnen wel voor nakomelingen zorgen
kunnen niet voor nakomelingen zorgen verklaring
Bekijk de voorgaande tabel opnieuw.
Welke twee voorwaarden moeten er voldaan opdat voortplanting kan zorgen voor vruchtbare nakomelingen?
•
• Voortplanting betekent dat organismen van eenzelfde soort gaan zorgen voor nakomelingen. Door voortplanting wordt de soort in stand gehouden. Zowel planten als dieren kunnen zich voortplanten.
Verwante diersoorten kunnen ook nakomelingen krijgen. Een mannetjesleeuw en een vrouwtjestijger krijgen als nakomeling een lijger.
Deze nakomelingen zijn meestal zelf onvruchtbaar.
Schrijf onder elke afbeelding welk soort koppel er wordt afgebeeld.
Kies uit: heterokoppel – lesbisch koppel – homokoppel




Welke koppels kunnen zich niet op een natuurlijke manier voortplanten?
Waarom kunnen ze dat niet?
Welke cel van de man is nodig om voort te planten?
Welke cel van de vrouw is nodig om voort te planten?
Bij geslachtelijke voortplanting ontstaat een nieuw organisme na samensmelting van een eicel en zaadcel. De eicel komt van een vrouwelijk individu en de zaadcel van een mannelijk individu.
We bekijken een voordeel van geslachtelijke voortplanting aan de hand van twee voorbeelden.


Hoe verschillen de mensen op de eerste afbeelding van elkaar?
Hoe verschillen de appels op de tweede afbeelding van elkaar?
Welk voordeel zouden deze verschillen met zich meebrengen voor de soort?
Geslachtelijke voortplanting zorgt voor genetische variatie binnen een soort waardoor evolutie mogelijk is.
1.3 Ongeslachtelijke voortplanting
Bekijk de personen op de afbeelding.
Wat valt je op als je naar de personen kijkt?

Som twee lichamelijke kenmerken op die hetzelfde zijn bij deze personen.
Is het mogelijk dat deze persoon zich zonder partner heeft voortgeplant? Leg uit.
Bij ongeslachtelijke voortplanting ontstaat een nieuw organisme uit een deel van de ouder. De nakomelingen zijn identiek hetzelfde als de ouder.
Wanneer er een identiek exemplaar van een levend wezen wordt gemaakt, noemen we dat klonen. Benieuwd hoe dat in zijn werk gaat? Bekijk dan het filmpje.
Ongeslachtelijke voortplanting wordt ook wel aseksuele voortplanting genoemd.
Het eerste zoogdier dat succesvol gekloond werd, was het schaap Dolly.
Omwille van ethische redenen is het klonen van mensen verboden.
Opdracht 1
(Zie verder oefenen? 1 , 2 , 4 )
Verbind de twee types van voortplanting met hun kenmerk


Opdracht 2
Heb ik het begrepen? CHECK-UP
Exacte genetische kopieën worden gecreëerd.
Genetisch materiaal wordt gecombineerd. Dit creëert variatie in de soorten.
Twee cellen smelten samen. Doorgaans is er een grotere eicel en een kleinere zaadcel.
Hier komen geen mannelijke of vrouwelijke geslachtscellen aan te pas. Voortplanting gebeurt hier door middel van celsplitsing, knopvorming …
(Zie verder oefenen? 3 , 4 , 5 , 6 , 7 )
Lees de teksten hieronder en plaats het cijfer van elke afbeelding op de volgende pagina naast de juiste omschrijving.
Besluit vervolgens of het organisme zich geslachtelijk of ongeslachtelijk voortplant. Kruis het juiste antwoord onder elke foto aan. Soms zijn beide opties mogelijk.
Bij het enten wordt een deel van een plant (een ent) op een deel van een andere plant (de onderstam) vastgemaakt. Dit doet men om een bepaalde soort sterker te maken of om een betere opbrengst te verkrijgen.
Na de paring kan bij bepaalde diersoorten het vrouwtje de neiging hebben om het mannetje te doden. Zo eet het vrouwtje van de bidsprinkhaan (die groter is dan het mannetje) na de daad haar bedpartner soms op.
Bacteriën vermenigvuldigen zich razendsnel door zich telkens in twee te splitsen.
Koralen op de zeebodem zijn opgebouwd uit poliepen, dat zijn kleine organismen. Sommige koralen planten zich voort via knopvorming. Dat betekent dat de poliepen zich splitsen en vermenigvuldigen.
Bepaalde soorten mannelijke sponzen stoten massaal spermacellen uit. Die komen met de stroming van het zeewater de vrouwelijke spons binnen.
Een bijenkoningin produceert mannelijke darren en vrouwelijke werkbijen. Door chemische stoffen van de koningin worden de werksters onvruchtbaar gehouden.
Merkwaardig genoeg ontstaan darren dan weer uit onbevruchte eicellen.
Mannelijke en vrouwelijke zeesterren laten respectievelijk grote hoeveelheden spermacellen en eicellen met de stroming wegzweven. Sommige zeesterren werpen ook af en toe een armpje af. Uit deze arm groeit dan een nieuwe zeester.
Bij bloemplanten worden vrouwelijke bloemen door stuifmeel uit mannelijke bloemen bevrucht. Hier speelt de wind een grote rol in, maar ook diertjes zoals bijen, die tot de bloemen worden aangetrokken, helpen hieraan mee.
Opdracht 3 (Zie verder oefenen? )


geslachtelijk ongeslachtelijk
1 geslachtelijk ongeslachtelijk

3 geslachtelijk ongeslachtelijk
5 geslachtelijk ongeslachtelijk 7

geslachtelijk ongeslachtelijk

2 geslachtelijk ongeslachtelijk

geslachtelijk ongeslachtelijk

geslachtelijk ongeslachtelijk
1.4 Verder oefenen?
1 Bekijk de afbeelding. Kruis aan of er sprake is van geslachtelijke of ongeslachtelijke voortplanting.

Geslachtelijke voortplanting Ongeslachtelijke voortplanting
Geslachtelijke voortplanting Ongeslachtelijke voortplanting
2 Duid aan welke wijze van voortplanting gebruikt wordt.
geslachtelijke voortplanting ongeslachtelijke voortplanting
Een vrouwelijk schaap en een ram zorgen voor kleine lammetjes.
Wanneer de arm van een zeester afbreekt, kan die arm uitgroeien tot een nieuwe zeester.
Een afgeknipt takje van een bananenplant groeit opnieuw uit tot een plant.
Een jongen en een meisje vrijen onveilig. Na enkele weken merkt het meisje dat ze zwanger is.
3 Kunnen een mannelijke hond en een vrouwelijke kat zich voortplanten? Verklaar je antwoord.
4 Markeer de begrippen die horen bij ongeslachtelijke voortplanting in het groen. Markeer de begrippen die horen bij geslachtelijke voortplanting in het geel.
kans op evolutie van de soort geen genetische diversiteit nakomeling uit versmelting van zaadcel en eicel genetisch identieke nakomelingen aan de ouder genetische diversiteit zeer snelle vermeerdering van de soort voortplanting zonder partner nakomeling uit een deel van de ouder
5 Noteer de voortplantingswijze aan en kruis ook aan of de uitspraak een voor- of een nadeel van die voortplantingswijze is.
uitspraak geslachtelijk (G) of ongeslachtelijk (O)? voordeelnadeel
Er is slechts één ouder nodig.
Elk organisme heeft een partner nodig om zich voort te planten.
Het is eenvoudig om veel identieke organismen te krijgen.
De groep organismen groeit langzaam omdat enkel de vrouwelijke individuen jongen kunnen baren.
Er ontstaat geen genetische variatie binnen de soort.
6 Een paard en een ezel kunnen paren en een nakomeling krijgen. De nakomeling is een muildier (paardenmerrie + ezelhengst) of een muilezel (ezelin + paardenhengst) en wordt gefokt voor zijn kracht en uithoudingsvermogen. Deze kruisingen zijn meestal wel onvruchtbaar. Hoe kan je dit verklaren?

7 Stel er breekt een nieuwe ziekte uit bij organismen die zich enkel en alleen ongeslachtelijk kunnen voortplanten. Waarom is dit een probleem? Leg uit.
2.1 Voedsel op voorraad
Oriëntatie
Onderzoeksvraag
Hoe kan je geoogste groenten opnieuw laten groeien?
Hypothese
Ik denk dat
Voorbereiding
Materiaal
Aardappel Ajuin
Uitvoering
Stappenplan
Wortel Ondiepe schaal Water
1 Vul een ondiepe schaal met een klein beetje water.
2 Leg de groenten in de schaal en plaats deze op een lichtrijke plaats.
3 Wacht enkele dagen.
Resultaten
Welk resultaat neem je waar na een week? Teken wat je ziet op de afbeeldingen.



Reflectie
Besluit
Welke wijze van voortplanting vindt hier plaats? GESLACHTELIJK / ONGESLACHTELIJK
Hoe weet je dit?
Wat valt er op aan het uiterlijk van een aardappel, wortel en ajuin?
Waarom zijn deze plantendelen verdikt?
Sommige planten kunnen zich ongeslachtelijk voorplanten door bepaalde plantendelen (zoals stengel, wortel…) te laten uitgroeien tot een nieuwe plant. Deze plantendelen bevatten reservestoffen die dienen als voedingsstoffen voor de nakomelingen om zich verder te ontwikkelen.
Aan de ongeslachtelijke voortplanting van planten zijn ook een aantal voordelen verbonden.
Juist of fout? Noteer voor elke bewering een kruisje in de juiste kolom.
Zaden worden gebruikt om planten ongeslachtelijk te laten voortplanten.
Een nadeel van ongeslachtelijk voortplanten is dat niet alle nakomelingen gelijk zijn.
Als een moederplant zich ongeslachtelijk vermenigvuldigt, verdwijnen de slechte eigenschappen bij de dochterplanten.
Een voordeel van ongeslachtelijke voortplanting is dat je niet op zoek moet naar een partner.
2.2 Technieken voor ongeslachtelijke voortplanting bij planten
De mens helpt de natuur soms een handje door kunstmatig te zorgen voor de ongeslachtelijke voortplanting van planten. Hieronder zie je een aantal technieken.
Verbind de afbeelding met de juiste omschrijving.


Enten
Er wordt een deel van de ene plant vastgemaakt aan een andere plant. De twee delen vergroeien en worden één plant.
Stekken
Een deel van de ene plant wordt afgeknipt en in water geplaatst. Dit deel groeit uit tot een nieuwe plant.
Afleggen
Een tak van de plant wordt omgebogen zodat deze onder de grond zit. Op die plek vormen zich wortels en groeit een knop uit tot een nieuwe plant.
Naam:
Klas: Datum: / /
Voortplanting bij planten
Oriëntatie
Je onderzoekt verschillende manieren van ongeslachtelijke voortplanting bij planten en leert:
• welke technieken er zijn
• hoe nieuwe planten ontstaan zonder zaden
• wat de overeenkomsten en verschillen zijn tussen deze technieken
Voorbereiding
Benodigdheden (per groepje)
• Stekje (bijv. geranium, basilicum of kamerplant)
• Aardappel (met “ogen”)
• Tulp- of ui-bol
• Aardbeienplant
• Potjes met aarde
• Schaar of mesje
• Water
• Labels en pen
Uitvoering
Je werkt met meerdere technieken. Niet alles hoeft tegelijk echt geplant te worden; deels observeren/beschrijven is ook goed.
Werkwijze
Deel A – Stekken
1 Knip een stek van de plant (± 10 cm, met blad).
2 Verwijder de onderste bladeren.
3 Zet de stek in water of in aarde.
4 Geef het potje een label met datum en naam.
Deel B – Knollen (aardappel)
1 Bekijk de aardappel.
2 Zoek de “ogen”.
3 Snijd de aardappel (indien nodig) in stukken met elk een oog.
4 Leg of plant één stuk in een potje met aarde.
Deel C – Bollen
1 Bekijk een bol (of afbeelding).
2 Zoek waar de wortels en scheut zitten.
3 Beschrijf hoe uit één bol meerdere nieuwe bollen kunnen ontstaan.

Deel D – Uitlopers
1 Bekijk een aardbeienplant (of afbeelding).
2 Zoek de uitlopers.
3 Beschrijf hoe hieruit een nieuwe plant ontstaat.



Waarnemingen
Vul de tabel in:
techniekgebruikt plantendeelontstaan zaden?aantal ouderplanten stekken
knollen bollen
uitlopers
Vragen
1 Wat hebben alle vormen van ongeslachtelijke voortplanting met elkaar gemeen?
2 Noem één voordeel van ongeslachtelijke voortplanting voor planten.
3 Noem één nadeel van ongeslachtelijke voortplanting.
4 Waarom zijn de nieuwe planten genetisch gelijk aan de ouderplant?
5 Welke techniek lijkt jou het snelst? Leg je antwoord uit.
Reflectie
Besluit
Schrijf een korte conclusie (3–4 zinnen) waarin je uitlegt:
• wat ongeslachtelijke voortplanting is
• welke technieken je hebt onderzocht
• wat je belangrijkste conclusie is
Uitdaging
• Bedenk welke techniek het meest geschikt is voor landbouw.
• Vergelijk één techniek met geslachtelijke voortplanting.
Naast de kunstmatige manieren, zijn er ook een aantal natuurlijke manieren waarop een plant zorgt voor ongeslachtelijke voortplanting.
Verbind de plant met de correcte manier.
Bol
Een ondergronds opslagorgaan van een plant dat voedingsstoffen bevat. Hieruit groeit elk jaar een nieuwe plant, dankzij de vlezige rokken die energie opslaan en het groeipunt waaruit stengel en bladeren ontstaan.
Knol
Een verdikt ondergronds plantendeel waarin voedingsstoffen worden opgeslagen en waaruit een nieuwe plant kan groeien.
Uitloper
Een horizontale stengel die zich van de moederplant uitbreidt en op een nieuwe plek kan uitgroeien tot een nieuwe plant.



Wortelstok
Een ondergrondse, horizontale stengel waarin voedingsstoffen worden opgeslagen en waaruit nieuwe scheuten en wortels groeien.
Broedknop
Een knop waaruit een nieuwe plant kan ontstaan en die los kan raken van de moederplant.


CHECK-UP
Heb ik het begrepen?
Opdracht 4
(Zie Verder oefenen? 8 , 9 , 10 , 11 )
Beoordeel de uitspraken met waar of niet waar.
a Bij ongeslachtelijke voortplanting is maar één ouder nodig.
b Nakomelingen zijn genetisch verschillend van de ouderplant.
c Stekken is een vorm van ongeslachtelijke voortplanting.
d Bij ongeslachtelijke voortplanting ontstaan zaden.
Opdracht 5
(Zie Verder oefenen? 10 , 11 )
Een aardappelplant maakt nieuwe aardappels.
a Is dit geslachtelijke of ongeslachtelijke voortplanting?
b Leg kort uit waarom.
Opdracht 6
(Zie Verder oefenen? 13 )
Noem één voordeel van ongeslachtelijke voortplanting.
Opdracht 7
(Zie Verder oefenen? 14 , 15 )
Noem één nadeel van ongeslachtelijke voortplanting.
waarniet waar
2.3 Verder oefenen?
8 Wat is een kenmerk van ongeslachtelijke voortplanting?
a Twee ouders
b Bevruchting
c Genetisch identieke nakomelingen
d Vorming van bloemen
9 Welke manier hoort bij ongeslachtelijke voortplanting?
a Bestuiving
b Bevruchting
c Stekken
d Zaadvorming
10 Koppel elk begrip aan de juiste omschrijving:
verdikte ondergrondse stengel met reservevoedsel stekken
nieuwe plant groeit uit een deel van de ouderplant uitlopers
ondergrondse opslag met bladeren knollen
horizontale stengels waar nieuwe planten aan groeien bollen
11 Welke plant plant zich ongeslachtelijk voort met bollen?
a Aardbei
b Tulp
c Aardappel
d Paardenbloem
12 Wat gebeurt er bij stekken?
a Een zaad groeit uit tot een plant
b Een bloem wordt bestoven
c Een deel van de plant groeit uit tot een nieuwe plant
d Twee geslachtscellen versmelten
13 Waarom is ongeslachtelijke voortplanting handig voor tuiniers? Verklaar.
14 Waarom kan ongeslachtelijke voortplanting een nadeel zijn bij ziekte? Leg uit.
15 Een plantensoort plant zich al generaties lang alleen ongeslachtelijk voort.
Leg uit wat dit betekent voor de genetische variatie binnen deze soort.
3.1 Voortplantingsorganen van een bloemplant
Welke allergie heeft de man op de foto?
In welk seizoen is deze allergie het ergste?
Wat verspreidt er zich vooral door de lucht in dit seizoen?

Uit welk deel van de plant is dit afkomstig? WORTEL / STENGEL / BLOEM / BLAD
Waarom wordt dit verspreid?
Delen van de bloem
Benoem de aangeduide delen op de afbeelding. Kies uit: kelkbladeren – stamper – meeldraad – kroonbladeren
Het vrouwelijk voortplantingsorgaan. Hier worden de eicellen geproduceerd:
De mannelijke voortplantingsorganen. Deze ontwikkelen stuifmeelkorrels, ook wel pollen genoemd:




























Deze bladeren bieden bescherming aan de bloem voordat deze uitkomt:




























































Deze bladeren lokken insecten, die zorgen voor de bevruchting:
Bloemen dragen de voortplantingsorganen van een plant. De meeldraad is het mannelijk geslachtsorgaan van een plant en bevat de zaadcellen. De stamper is het vrouwelijk geslachtsorgaan van een plant en bevat de eicellen.
Bloemen kunnen eenslachtig of tweeslachtig zijn.
De voortplantingsorganen van een plant bevinden zich op de bloemen. Beiden zijn deze organen aangepast aan hun functie op een specifieke manier.
Bekijk de macroscopische bouw van een meeldraad van een plant.
Noteer de begrippen op een correcte plaats. Kies uit: meeldraad – stuifmeelkorrels – helmknop –helmdraad. tweeslachtige bloem eenslachtige bloem (mannelijke bloem) eenslachtige bloem (vrouwelijke bloem)
Bekijk de macroscopische bouw van een stamper van een plant.
Noteer de begrippen op een correcte plaats. Kies uit: stijl – stamper – stempel – vruchtbeginsel – zaadbeginsel – eicel
3.2 Bestuiving
Je leerde hiervoor al dat de zaadcel en eicel met elkaar moeten versmelten om aan geslachtelijke voortplanting te doen. Dit betekent dus dat de eicel en zaadcel met elkaar in contact moeten komen.
Bekijk de afbeeldingen en noteer op welke manier de zaadcellen (stuifmeel) van de plant worden verspreid.



Waar moet dit stuifmeel terechtkomen bij de andere plant om zich te kunnen voortplanten?
Het overbrengen van stuifmeel van de meeldraad naar de stamper van eenzelfde soort bloem noemen we bestuiving. Dat kan gebeuren door insecten, de wind, de mens ...
Bekijk de afbeelding en plaats de nummers op de correcte plaats op de tekening.
1 meeldraad
2 stuifmeel (zaadcellen)
3 stamper
4 bestuiver
5 vruchtbeginsel met eicellen
Je kwam al te weten dat bestuiving bij planten kan gebeuren door bestuivers die in de natuur voorkomen. We maken een onderscheid tussen insectenbloeiers en windbloeiers
kenmerk insectenbloeier windbloeier
De kroonbladeren zijn …
FEL GEKLEURD / AMPER GEKLEURD
De bloemen hebben … GEUR / GEEN GEUR
Het aantal stuifmeel is …
FEL GEKLEURD / AMPER GEKLEURD
GEUR / GEEN GEUR
VEEL / WEINIG VEEL / WEINIG
Er zijn nectarklieren … AANWEZIG / NIET AANWEZIGAANWEZIG / NIET AANWEZIG
De stuifmeelkorrels zijn …LICHT / PLAKKERIG LICHT / PLAKKERIG
Bestuiving kan ook op verschillende manieren gebeuren en planten hebben zich vaak aangepast aan een specifieke soort bestuiving.
Verbind de omschrijving met de correcte afbeelding.
kruisbestuiving
Stuifmeel komt op een andere bloem, die op dezelfde plant zit, terecht.
zelfbestuiving
Stuifmeel komt op de stempel van dezelfde bloem terecht.
buurbestuiving
Het stuifmeel bereikt de stamper van een andere bloem op een andere plant.
Op de afbeelding zie je het verloop van de geslachtelijke voortplanting bij een bloemplant. Beantwoord de vragen.
Welke 2 geslachtscellen zijn nodig voor geslachtelijke voortplanting?
Welk orgaan van de bloemplant levert de zaadcel?
Welk orgaan van de bloemplant levert de eicel?
Waar in de bloemplant zullen de 2 geslachtscellen met elkaar versmelten?
Op welk onderdeel van de stamper moet de stuifmeelkorrel terecht komen?
Wat groeit er vanuit de stuifmeelkorrel door de stamper om de eicel te bereiken?
Tot wat groeit het zaadbeginsel verder uit?
Bloemplanten gebruiken zaden, die ontstaan na samensmelting van een zaadcel en eicel, om zich geslachtelijk voort te planten. Zaden kunnen bij de ideale omstandigheden uitgroeien tot een nieuwe plant.
Planten die zich geslachtelijk voortplanten, doorlopen een hele levenscyclus. Planten met bloemen, zoals de tomaat hieronder, doen dan aan bestuiving. Hieronder zie je het hele proces van bestuiving tot vrucht tot zaadje.
Markeer in de volgende zinnen telkens de juiste optie. Let op, de zinnen staan niet in de juiste volgorde. Noteer vervolgens het nummer van de omschrijving op de juiste plaats bij de afbeelding.
1 In de vrucht / bloem zitten zaadjes of kiemen.
2 Als de bloemen volgroeid / bestoven zijn (door diertjes, de wind …), ontstaan er vruchten.
3 In de juiste omstandigheden ontstaat uit het zaadje een wortel. Ook de eerste blaadjes / bloemen ontwikkelen zich.
4 Op de bestoven / volwassen plant ontwikkelen zich bloemen.
5 In deze fase spreken we van een echt plantje, maar voor het kan rijpen / bloeien, moet het nog wat groeien.
6 De vruchten kiemen / rijpen en ontwikkelen zich tot volgroeide (en eetbare) exemplaren.
7 De plant is volgroeid / bestoven en zal weldra bloemen voortbrengen.
CHECK-UP
Heb ik het begrepen?
Opdracht 8
Plaats de afbeeldingen in de juiste volgorde.





Op welke foto kan er bestuiving plaatsvinden?
Waarom kan er bestuiving plaatsvinden?
Uit welk plantendeel worden de appels gevormd?
Wat stellen de pitjes (in een appel) voor?
Wat gebeurt er met deze pitjes wanneer je ze bij gunstige omstandigheden in de grond stopt?
3.5 Verder oefenen?
16 Verbind de afbeeldingen met de correcte functie en cel.

meeldraad

stamper
17 Welk proces in de geslachtelijke voortplanting van een plant zie je op de afbeelding hieronder?
produceert stuifmeel met zaadcellen
produceert eicellen en groeit uit tot een vrucht met zaden


18 Los de rebus op en beantwoord de vragen. - D


= I R = V
Welk woord kan je vinden na het oplossen van de rebus?
Wat betekent dit woord?
Bij welke organismen vindt dit proces plaats
19 Benoem de aangeduide delen van de bloem.
























































































20 Plaats de stappen van de geslachtelijke voortplanting bij planten in de correcte volgorde. bevruchting – bestuiving – kieming van het zaad – vorming van de zaden – groei van de vrucht verspreiding van zaad
21 Gaat het hier over een insectenbloeier of windbloeier? Verklaar je antwoord.

22 Zijn volgende uitspraken waar of niet waar? Noteer je antwoord. waarniet waar
Bij geslachtelijke voortplanting zijn altijd twee ouderplanten nodig.
Stuifmeel bevat de mannelijke geslachtscellen.
Bestuiving en bevruchting zijn hetzelfde.
Geslachtelijke voortplanting zorgt voor genetische variatie.
Na de bevruchting groeit het vruchtbeginsel uit tot een vrucht.
Zaden ontstaan zonder bevruchting.
In bloemen zitten de voortplantingsorganen van veel planten.
Bij zelfbestuiving komt stuifmeel van een andere plant.
De eicel bevindt zich in het vruchtbeginsel.
Alle planten planten zich geslachtelijk voort.
23 Koppel het begrip aan de juiste beschrijving: ontstaat na de bevruchting uit het vruchtbeginsel stuifmeel bevat de mannelijke geslachtscellen zaad het samensmelten van een eicel en een zaadcel vrucht ontstaat uit een bevruchte zaadbeginsel bevruchting
24 Een plant groeit in een kas zonder insecten. Hoe kan bestuiving toch plaatsvinden? Verklaar.
25 Waarom zijn bloemen vaak felgekleurd of geurig? Leg uit.
26 Sommige planten hebben eenslachtige bloemen. Leg uit hoe deze planten zich toch geslachtelijk kunnen voortplanten.
27 Een onderzoeker ontdekt dat een plantensoort vooral kleine, onopvallende bloemen heeft en veel licht stuifmeel produceert. Op welke manier vindt bestuiving plaats?
WOORDENLIJST
bestuiving
stuifmeel komt op stamper terecht van dezelfde of een andere bloem
bevruchting samensmelting van een zaad- en eicel genetische variatie verschil in erfelijk materiaal (DNA) tussen individuen van dezelfde soort
geslachtelijke voortplanting
zaadcel en eicel versmelten met elkaar en zorgen voor nakomelingen
kieming ontwikkeling van plant uit een zaad
ongeslachtelijke voortplanting nakomeling ontstaat uit deel van de ouder
voortplanting het zorgen voor nakomelingen voortplantingsorgaan orgaan met als functie voortplanting
STUDIEWIJZER
ik ken het!
paginanummer
Ik kan het begrip voortplanting uitleggen. p. 4-7
Ik kan voorbeelden geven van voortplantingswijzen. p. 7
Ik kan voortplantingswijzen herkennen in bepaalde situaties. p. 14-15
Ik kan voorbeelden geven van ongeslachtelijke voortplantingen bij planten. p.14
Ik kan de geslachtsorganen van een bloem aanduiden en herkennen. p. 18
Ik kan uitleggen hoe bloemen voortplanten door middel van bestuiving. p. 20-21
Ik kan de levenscyclus van een plant kort opnoemen. p. 23
Colofon
Auteur Tim Stoelen met medewerking van Diederik Maebe
Eerste editie
Bestelnummer 90 808 0522 (module 4 van 5)
ISBN 978 90 4865 286 0
KB D/2026/0147/022
NUR 126
Thema YPMP
Verantwoordelijke uitgever die Keure, Kleine Pathoekeweg 3, 8000 Brugge
RPR 0405 108 325 - © die Keure, Brugge
Niets uit deze uitgave mag verveelvoudigd en/of openbaar gemaakt worden door middel van druk, fotokopie, microfilm of op welke wijze ook zonder voorafgaande schriftelijke toestemming van de uitgever. No parts of this book may be reproduced in any form by print, photoprint, microfilm or any other means without written permission from the publisher. De uitgever heeft naar best vermogen getracht de publicatierechten volgens de wettelijke bepalingen te regelen. Zij die niettemin menen nog aanspraken te kunnen doen gelden, kunnen dat aan de uitgever kenbaar maken.
Die Keure wil het milieu beschermen. Daarom kiezen wij bewust voor papier dat het keurmerk van de Forest Stewardship Council® (FSC®) draagt. Dit product is gemaakt van materiaal afkomstig uit goed beheerde, FSC®-gecertificeerde bossen en andere gecontroleerde bronnen.